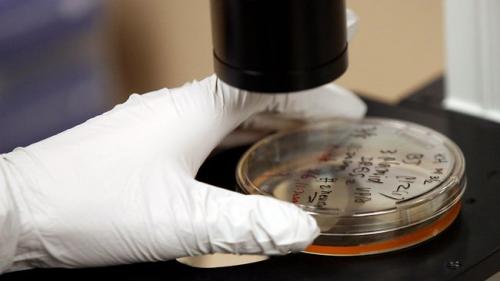
9 современных ученых, ставящих необычные эксперименты

9 современных ученых, ставящих необычные эксперименты
Австрийские исследователи вырастили в лаборатории мозг
Этот мозг не плавает в банке, скорее это «мозговые органоиды» всего 4 мм в диаметре, выращенные из стволовых клеток человека в чашке Петри.

Этот так называемый мини-мозг представляет собой первый случай, когда учёные смогли создать что-то близкое к мозговой ткани в лабораторных условиях. Безусловно, до разумной сущности ещё далеко, но благодаря мини-мозгу удалось узнать, как развивается редкое заболевание под названием микроцефалия. Кроме того, подобные образцы можно использовать для диагностики и лечения других заболеваний вроде аутизма и шизофрении.
Норвежский врач вывел женщину из состояния клинической смерти
Анна Багенхольм, врач из Наварика, Норвегия, в 1999-м году попала в ужасное происшествие, катаясь на горных лыжах.
На фото: Анна Багенхольм

Странное стечение обстоятельств привело к тому, что она находилась в ловушке подо льдом в течение 80-ти минут. Её оледенелое тело доставили на вертолёте в ближайшую больницу в часе езды от горнолыжного комплекса — женщина не подавала признаков жизни. Температура ее тела упала до 13,7 градусов.

Доктор Мадс Гилберт принял решение, спасшее ей жизнь — врачи медленно нагревали оледеневшее тело женщины, и три часа спустя сердце забилось снова. Багенхольм пошла на поправку, и её история стала маяком надежды для всех, кто был на «другой стороне».
На фото: Мадс Гилберт





































